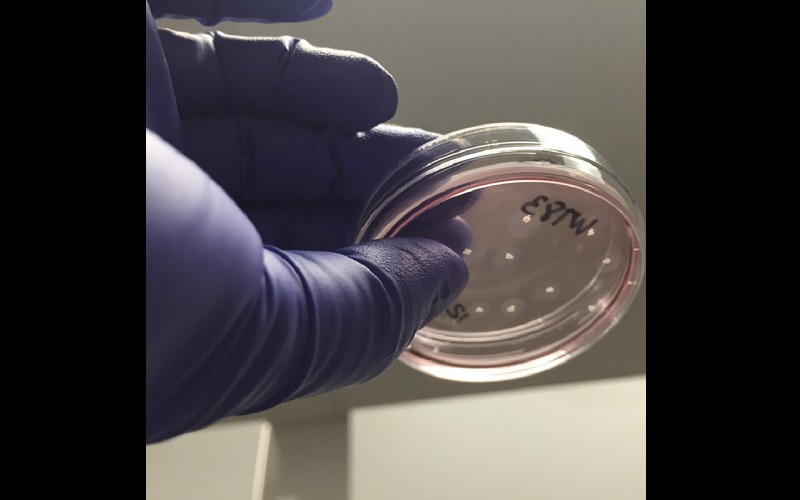
home page post

Entidades reagem com perplexidade à anulação de júris do Carandiru
Entidades de direitos humanos e advogados que acompanharam o caso reagiram com perplexidade e insatisfação à decisão de anulação do julgamento do massacre do Carandiru.
Banco Central bloqueia R$ 30,8 mi de Palocci
O Banco Central bloqueou R$ 30,8 milhões em contas bancárias do ex-ministro da Fazenda Antônio Palocci e de sua empresa, a Projeto Consultoria Empresarial e Financeira Ltda.
O Que há dentro do chocalho da cobra cascavel?
As cascavéis são répteis extremamente perigosos e que podem ter uma mordida letal. Essas cobras peçonhentas são dos gêneros Crotalus e Sistrurus, que possuem o conhecido e temido chocalho.
Eleições 2016: saiba o que é permitido na hora de votar
No próximo domingo, 02 de outubro, mais de dois milhões de alagoanos irão às urnas para escolher novos prefeitos e vereadores.
Os 10 criminosos mais procurados do Brasil
Proteja sua família, seu país e sua comunidade ajudando a POLÍCIA FEDERAL e a INTERPOL BRASIL a prender criminosos fugitivos.
Justiça anula júris que condenaram PMs por massacre do Carandiru
A promotoria e os advogados dos parentes das vítimas podem recorrer da decisão, que foi tomada por 2 votos a 1.
Temer telefonou para Faustão após ser criticado na TV, diz coluna
O presidente Michel Temer ficou chateado com a duras críticas do apresentador Faustão durante seu programa do último domingo (25).
Morre aos 93 anos o ex-premiê israelense Shimon Peres
Morreu na madrugada desta quarta-feira o ex-primeiro-ministro e ex-presidente de Israel, Shimon Peres, aos 93 anos, segundo o jornal inglês The Guardian.
Polícia Civil prende homem por homicídio no Sertão
Durante a ação, o acusado foi detido em flagrante com revólver no município de Batalha.
STF aceita denúncia contra Gleisi Hoffmann e Paulo Bernardo
A Segunda Turma da corte decidiu por unanimidade, 5 votos a 0, aceita a denúncia apresentada pela Procuradoria-Geral da República.
Primeiro filho de 'três pessoas' nasce a partir de nova técnica
Uma nova técnica de fertilização auxiliou no nascimento de um bebê gerado por três pessoas, segundo a revista científica "New Scientist".
Prefeito de Monteirópolis disse que jamais rejeitou receber notificação da Justiça
Sobre seu afastamento da prefeitura, Elmo Medeiros afirmou que já recorreu da decisão da Justiça porque é inocente dos crimes a ele imputados
Novo laboratório em SP cria 'minicérebros' para tratamento de autismo
Pesquisadores analisam genes de cada paciente para prever remédios cada vez mais certeiros para luta contra a doença
Cerco a Neymar deixa o Barcelona 'perplexa'
Há muita inquietação dentro do Barcelona a decisão da Justiça Espanhola de acatar o pedido do Ministério Público para a reabertura doo caso DIS, na última sexta-feira.
Saiba como justificar o voto neste domingo em Sergipe
Formulários estão disponíveis nos seções eleitorais. TRE disponibilizou a lista dos postos de justificativa em Aracaju.
Faltam 5 dias: celular e máquina fotográfica são proibidos na cabina de votação
A cabina de votação é o local reservado da seção eleitoral em que o eleitor pode expressar, com total sigilo e inviolabilidade, seu voto na urna eletrônica
Faltam 5 dias: propaganda de boca de urna no dia da eleição é proibida e constitui crime
É preciso ficar atento ao que diz a legislação para não sofrer sanções.
TJ de Alagoas divulga resultado final do concurso para juiz substituto
Serão preenchidas inicialmente 20 vagas e os demais aprovados ficarão em cadastro reserva; certame teve mais de quatro mil inscritos
Vereador de Palestina ganha salvo-conduto do TJ/AL e não pode ser preso até 4 de outubro
Luciano Farias teve prisão decretada pela 8ª Vara Criminal da Capital por homicídio qualificado; ele era considerado foragido da Justiça desde o dia 23
Ministério Público Estadual aguarda retomada de julgamento de recursos dos “taturanas” na próxima quinta-feira
A sessão foi suspensa na semana passada em virtude do pedido de vista feito pelo desembargador Fernando Tourinho, que teve dúvidas sobre a preliminar referente à citação para defesa do réu Arthur César Pereira de Lira
Bancários em greve e bancos voltam a renegociar nesta terça-feira
Greve dos bancários completou 21 dias nesta segunda-feira (26). Bancários pedem reposição da inflação mais 5% de aumento real.

Apa LuzBom dia. Na França/Paris comprei uma barra de chocolate popular de embalagem comum vermelha e branca de nome - talvez - Nunak - não tenho certeza. Chocolate muito gostoso - saberia me dizer qual Poderia ser? Obrigada
04 de Fevereiro de 2026 às 07:40:36Corine (turista europea)ume agencia do Banco do Brasil é indispensavél em Pao de Açucar (AL)
07 de Julho de 2025 às 20:59:13Claudia Oito anos se passaram e nada foi descoberto ???????????
17 de Junho de 2025 às 07:14:19